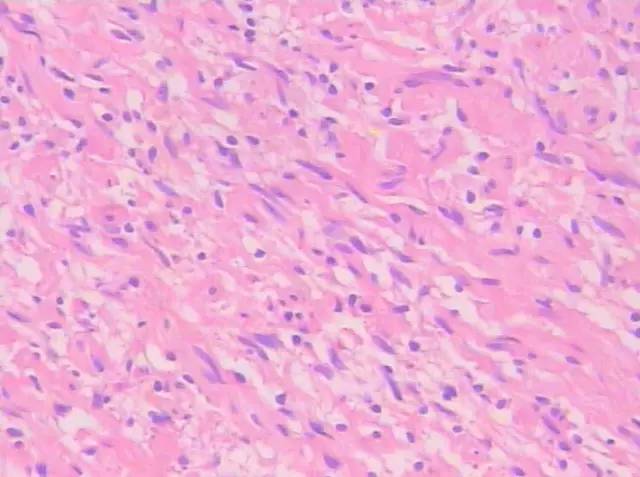

【临床资料】
患者,男,41岁。因尿急一月余来我院就诊,有下腹坠胀感,无腹痛、血尿、血精等症状。
实验室检查:血常规、生化、凝血、尿常规及肿瘤标记物化验未发现特殊异常。
影像检查:超声示盆腔内直肠中段左侧见一肿块图像,大小约4.4 cm×5.0 cm×3.2 cm,形状呈椭圆形,边界欠规整,内部为低回声,分布不均,后方回声无变化,彩色多普勒显示肿块内部可见少许点状血流信号。
【影像表现】
CT示左侧精囊区见一肿块,大小约4.3 cm×3.6 cm;平扫呈稍低密度(相对邻近肌肉密度),密度不均,其内可见散在分布更低密度区,CT值约18-28HU(图1),动脉期CT值20-28HU(图2),静脉期CT值20-30HU(图3),肿块边缘规整、边界清楚,与直肠膀胱分解清楚。

图1 CT平扫病灶呈稍低密度,边界清楚

图2 CT增强动脉期示病灶无强化

图3 CT增强静脉期示病灶无强化
———-♀【病例讲堂】分割线♀———
小编留言:现在TA是你的病人了,在等你诊断哦!给大脑洗澡的时候到了,有思考才有收获!
【病理结果】
肉眼所见左侧精囊灰黄色包块,大小约4.5 cm×3.2 cm×2.6 cm,切面灰黄实性,质嫩。光镜下示瘤细胞核小,卵圆,无明显的细胞突起,为梭形细胞肿瘤(图4、5);免疫组化:S-100( ),EMA(-),CK(-),VIM( ),CD34(部分 ),CD117(-)(图6)。

图4、5 镜下示瘤细胞核小,卵圆,无明显的细胞突起(图4X100,图5X200,HE)

图6 免疫组化图示S-100( )
【鉴别诊断】
影像诊断:精囊占位,考虑良性肿瘤。
病理诊断:符合神经纤维瘤。
【最后诊断】
(原发性精囊)孤立性神经纤维瘤
【讨论】
神经纤维瘤是指起源于神经鞘细胞的一种良性的周围神经瘤样增生性病变,由Schwann细胞、神经束膜样细胞和纤维母细胞构成的肿瘤。一般所指的神经纤维瘤又称孤立性神经纤维瘤(solitary neurofibroma)。临床男女发病无明显差别,好发年龄为20-40岁。肿瘤可发生于周围神经的任何部位,多见于躯干、四肢、头颈皮肤及皮下组织,也可发生在神经末梢或沿神经干的任何部位,如纵隔和腹膜后等部位。
神经鞘膜来源肿瘤内常见两种不同密度的实体成分即细胞致密区(Antoni A 区)和细胞稀疏区( Antoni B 区)[1]。神经鞘膜来源肿瘤的密度与Antoni A 区和Antoni B 区的比例、分布和排列有关;富细胞区为主或者只含有富细胞区, 病变密度较高,强化较明显; 细胞稀疏区为主或者只含有细胞稀疏区时, 肿瘤密度很低,强化不明显。本例肿块在光镜下可见细胞稀少及疏松网状背景,考虑肿瘤以细胞稀疏区为主;超声示肿块内部为低回声,后方回声无变化,彩色多普勒显示肿块内部可见少许点状血流信号;CT示肿瘤密度较低,几无强化;其影像表现与病理相符。
在临床中,原发性精囊腺肿瘤非常少见;至2006 年,较为公认的病例约69例[2]。其中,原发性精囊神经源性肿瘤临床罕见,病理学上分为良性和恶性,常见的组织类型有神经鞘瘤和神经纤维瘤。神经纤维瘤分为孤立性和多发性,多发性神经纤维瘤与神经纤维瘤病Ⅰ型相关。至今,国内外文献报道精囊原发性神经源性肿瘤仅有6例,均为神经鞘瘤;原发性精囊孤立性神经纤维瘤尚未见文献报道。
本例需要发生在精囊的其他肿瘤相鉴别,如精囊囊肿、精囊恶性肿瘤等。一般,精囊囊肿CT呈低密度,密度均匀,彩色多普勒显示无血流信号;而本例密度不均,并可见少许点状血流信号,支持病灶为实性肿块。另外,精囊恶性肿瘤大多数血供丰富,边缘模糊,易侵犯邻近组织结构。
因精囊位置深在,故在肿瘤早期,精囊肿瘤患者通常无自觉症状,一般在体检[3]或者瘤体增大压迫周围组织产生相应症状时发现。文献报道[4-5]可见右下腹痛、夜尿增多、尿频和直肠症状等。本例虽为精囊良性肿瘤,但体积较大,压迫膀胱左后壁压迫,患者有尿急症状。一般来说,直肠指检和超声结合直肠指诊是精囊肿瘤的初筛手段;而CT 和MRI 可进一步评估肿瘤的大小、位置及与周围脏器、组织黏连情况[5],为治疗方案提供依据。由于且精囊手术难度较大,有损伤性神经导致术后勃起功能障碍的可能。因此治疗方案需综合考虑肿瘤体积及患者意愿。
综上所述,尽管发生于精囊的神经源性肿瘤极为罕见,但神经纤维瘤的病理组织学和CT表现具有一定特征。故当CT检查发现精囊肿瘤且影像学呈良性表现时,应将神经源性肿瘤纳入考虑范围之内。
 纵隔大细胞神经内分泌癌1例CT影像
纵隔大细胞神经内分泌癌1例CT影像  张力性纵隔气肿影像表现及严重度分级
张力性纵隔气肿影像表现及严重度分级  迅速增大的肺部结节,首先考虑良性,确诊需要肺穿
迅速增大的肺部结节,首先考虑良性,确诊需要肺穿  肺隔离症:易误诊为肺癌的占位性病变,肺穿刺禁忌!
肺隔离症:易误诊为肺癌的占位性病变,肺穿刺禁忌!  肺段与肺内管道应用解剖
肺段与肺内管道应用解剖  肺转移瘤的十种不典型CT表现
肺转移瘤的十种不典型CT表现  肺内淋巴结的CT表现特点及与病理对照
肺内淋巴结的CT表现特点及与病理对照  肺实变与肺不张的CT鉴别诊断
肺实变与肺不张的CT鉴别诊断  医生现身说法,这五种忙帮不得!
医生现身说法,这五种忙帮不得!  北大教授:要真正让医务人员有阳光体面的收入!医
北大教授:要真正让医务人员有阳光体面的收入!医  为值夜班的医生护士鼓与呼:请给我们更多关注!
为值夜班的医生护士鼓与呼:请给我们更多关注!  广东拟取消医院用药数量限制,满足患者多样性需求
广东拟取消医院用药数量限制,满足患者多样性需求  博士、硕士入职就给精装房!又有医院不惜下血本招
博士、硕士入职就给精装房!又有医院不惜下血本招  历时7年之久,温医生宣判无罪!
历时7年之久,温医生宣判无罪!  重磅!四川发文:严禁限制医生多点执业
重磅!四川发文:严禁限制医生多点执业  与真人医生诊断一致性达96%:AI医生应用前景广阔
与真人医生诊断一致性达96%:AI医生应用前景广阔 



